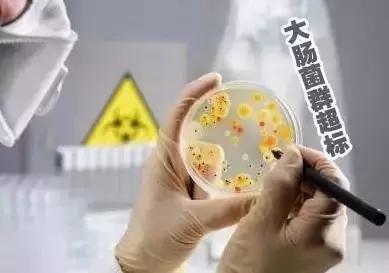
博白人注意!这些牌子的食品、饮料不合格!也许你常买!

近期,广西壮族自治区食品药品监督管理局组织抽检方便食品、肉制品和饮料等3类食品,共发现不合格样品18批次。根据食品安全国家标准,个别项目不合格,该样品即判定为不合格产品。

具体情况公告如下:
抽检总体情况
所有抽检样品遵循随机抽样原则。抽检发现不合格方便食品样品4批次;不合格肉制品样品2批次;不合格饮料样品12批次。
此次抽检中饮料是“重灾区”啊!
爱喝饮料的小伙伴们一定要看仔细,
避免购买到不合格产品哦!

不合格样品产品情况
(一)河池市南城百货有限公司销售的标称“桂林周氏顺发食品有限公司”生产的“黑珍四宝黑芝麻糊(方便食品)”样品(商标:周氏及图形商标,生产日期/批号:2017-08-15,规格:700克/袋),霉菌检出值为(1)40CFU/g; (2)55CFU/g; (3)50CFU/g; (4)420CFU/g; (5)70CFU/g,标准规定检出值为n=5;c=2;m=50CFU/g;M=100CFU/g。样品检验机构为广西—东盟食品药品安全检验检测中心。
(二)贺州市八步区辰易综合商行销售的标称 “ 玉林市欧氏川仔食品有限公司”生产的“海鲜米线(调味面制食品)”样品(商标:欧氏川仔及图形商标,生产日期/批号:2017-09-07,规格:18克/袋),山梨酸及其钾盐(以山梨酸计)检出值为0.23g/kg,标准规定不得使用。样品检验机构为广西—东盟食品药品安全检验检测中心。
(三)贺州市八步区诚信杂货商行销售的标称 “玉林市玉州区湘平食品厂”生产的“开胃牛(调味面制品)”样品(商标:/,生产日期/批号:2017-08-14,规格:22克/袋),菌落总数检出值为48000CFU/g,标准规定检出值为≤10000CFU/g;大肠菌群检出值为2400MPN/100g,标准规定检出值为≤90MPN/100g;样品检验机构为广西—东盟食品药品安全检验检测中心。
(四)金城江区晟敏食品批发部销售的标称“南宁市长寿奥秘食品厂”生产的“巴马富硒火麻糊”样品(商标:長夀者壹號(艺术字),生产日期/批号:2017-09-07,规格:360g/袋),霉菌检出值为(1)60CFU/g; (2)210CFU/g; (3)40CFU/g; (4)50CFU/g; (5)220CFU/g,标准规定检出值为n=5;c=2;m=50CFU/g;M=100CFU/g。样品检验机构为广西—东盟食品药品安全检验检测中心。
(五)叠彩区文涛食品商行销售的标称“东兴瑞和食品有限公司”生产的“泡凤爪”样品(商标:卤之深及图形商标,生产日期/批号:2017-09-01,规格:35克/袋),菌落总数检出值为(1)90CFU/g; (2)27000CFU/g; (3)16000CFU/g;(4)40CFU/g;(5)51000CFU/g,标准规定检出值为n=5;c=2;m=10000CFU/g;M=100000CFU/g。样品检验机构为广西—东盟食品药品安全检验检测中心。
(六)南宁市瑞凌食品经营部销售的标称“淇县健泰食品有限责任公司”生产的“香酥猪蹄”样品(商标:/,生产日期/批号:2017-09-10,规格:140克/袋),菌落总数检出值为(1)370000CFU/g; (2)12000CFU/g; (3)440000CFU/g; (4)320000CFU/g; (5)650000CFU/g,标准规定检出值为n=5; c=2; m=10000CFU/g; M=100000CFU/g。样品检验机构为广西—东盟食品药品安全检验检测中心。
(七)广西旅发集团山泉有限公司销售的标称“广西旅发集团山泉有限公司”生产的“旅宝美泉包装饮用水”样品(商标:旅宝美泉,生产日期/批号:2017-09-19,规格:350ml/瓶),溴酸盐检出值为0.012mg/L,标准规定检出值为≤0.01mg/L。初检机构为广西—东盟食品药品安全检验检测中心,复检机构为广西壮族自治区产品质量检验研究院。
(八)贵港市春源饮品有限公司销售的标称“贵港市春源饮品有限公司”生产的“荷城包装饮用水”样品(商标:荷城及图形商标,生产日期/批号:2017-09-20,规格:18.9L/桶),铜绿假单胞菌检出值为①<1CFU/250mL;②1CFU/250mL;③2600CFU/250mL;④72000CFU/250mL;⑤1CFU/250mL,标准规定检出值为n=5;c=0;m=0CFU/250mL。样品检验机构为广西—东盟食品药品安全检验检测中心。
(九)贵港市港北区绿叶副食品经销部销售的标称 “玉林市金羊饮料厂”生产的“冰糖雪梨(风味饮料) ”样品(商标:五羊及图形商标,生产日期/批号:2017-09-19,规格:250ml/瓶),菌落总数检出值为(1)3200CFU/mL; (2)36000CFU/mL;(3)68000CFU/mL;(4)52000CFU/mL;(5)36000CFU/mL,标准规定检出值为n=5;c=2;m=100CFU/mL;M=10000CFU/mL。样品检验机构为广西—东盟食品药品安全检验检测中心。
(十)河池市金城江大洋商贸有限责任公司销售的标称“广西中源山泉有限公司”生产的“九千万饮用天然泉水”样品(商标:九千万山泉,生产日期/批号:2017-07-15,规格:350ml/瓶),溴酸盐检出值为0.015mg/L,标准规定检出值为≤0.01mg/L。样品检验机构为广西—东盟食品药品安全检验检测中心。
(十一)贺州市八步区诚信杂货商行销售的标称“南宁昊大食品有限公司”生产的“冰糖雪梨(雪梨味饮料)”样品(商标:昊客及图形商标,生产日期/批号:2017-08-21,规格:180ml/杯),菌落总数检出值为(1)230CFU/mL;(2)140CFU/mL; (3)240CFU/mL;(4)170CFU/mL; (5)180CFU/mL,标准规定检出值为n=5;c=2;m=100CFU/mL;M=10000CFU/mL。样品检验机构为广西—东盟食品药品安全检验检测中心。
(十二)贺州市八步区禾生杂货经营部销售的标称“贺州市八步区莲塘康乐饮料食品厂”生产的“福牛味饮料”样品(商标:/,生产日期/批号:2017-09-18,规格:250毫升/瓶),酵母检出值为220CFU/mL,标准规定检出值为≤20CFU/mL。样品检验机构为广西—东盟食品药品安全检验检测中心。
(十三)金城江区金浩水行销售的标称“河池市沁乐泉天然泉水有限责任公司”生产的“沁乐泉包装饮用水(天然泉水)”样品(商标:QINLEQUAN及图形商标,生产日期/批号:2017-09-24,规格:18L/桶),铜绿假单胞菌检出值为①<1CFU/250mL;②<1CFU/250mL;③1CFU/250mL;④<1CFU/250mL;⑤<1CFU/250mL,标准规定检出值为n=5;c=0;m=0CFU/250mL。样品检验机构为广西—东盟食品药品安全检验检测中心。
(十四)罗城仫佬族自治县豪佳综合经营部销售的标称“河池市金城江区富成饮料厂”生产的“可乐味饮料”样品(商标:蜜浪及图形商标,生产日期/批号:2017-07-28,规格:260ml/瓶),二氧化碳气容量检出值为0.78倍,标准规定检出值为≥1.5倍。样品检验机构为广西—东盟食品药品安全检验检测中心。
(十五)天峨县东兰山泉经营部销售的标称“东兰山泉水业有限公司”生产的“包装饮用水(饮用天然泉水)”样品(商标:/,生产日期/批号:2017-09-24,规格:18L/桶),铜绿假单胞菌检出值为①<1CFU/250mL;②4CFU/250mL;③<1CFU/250mL;④42CFU/250mL;⑤10CFU/250mL,标准规定检出值为n=5;c=0;m=0CFU/250mL。样品检验机构为广西—东盟食品药品安全检验检测中心。
(十六)宜州市老王食品经营部销售的标称“广西南丹桂缘饮品有限公司”生产的“真牛(混合型果味饮料)”样品(商标:高思远,生产日期/批号:2017-09-20,规格:228ml/瓶),菌落总数检出值为(1)13000CFU/mL; (2)13000CFU/mL;(3)11000CFU/mL;(4)12000CFU/mL;(5) 12000CFU/mL,标准规定检出值为n=5;c=2;m=100CFU/mL;M=10000CFU/mL。样品检验机构为广西—东盟食品药品安全检验检测中心。
(十七)宜州市小七孔饮用水经营部销售的标称“广西河池市状元山生态山泉有限公司”生产的“状元泉包装饮用水”样品(商标:冯京状元泉(艺术字),生产日期/批号:2017-09-25,规格:18L/桶),铜绿假单胞菌检出值为①<1CFU/250mL;②<1CFU/250mL;③14CFU/250mL;④72000CFU/250mL;⑤3CFU/250mL,标准规定检出值为n=5;c=0;m=0CFU/250mL;样品检验机构为广西—东盟食品药品安全检验检测中心。
(十八)宜州市小七孔饮用水经营部销售的标称“宜州市宜山泉水业有限公司”生产的“宜山泉(包装饮用水)”样品(商标:/,生产日期/批号:2017-09-24,规格:18.9L/桶),铜绿假单胞菌检出值为①1CFU/250mL;②<1CFU/250mL;③1CFU/250mL;④<1CFU/250mL;⑤67000CFU/250mL,标准规定检出值为n=5;c=0;m=0CFU/250mL。样品检验机构为广西—东盟食品药品安全检验检测中心。
对抽检不合格食品查处情况
对上述抽检中发现的不合格食品,各相关市、县(市、区)食品药品监管部门均已经依法进行处置。

部分检验项目说明
大肠菌群
大肠菌群是国内外通用的食品污染常用指示菌之一。食品中检出大肠菌群,提示被致病菌(如沙门氏菌、志贺氏菌、致病性大肠杆菌)污染的可能性较大。本次检出大肠菌群超标的样品均未检出致病菌。结合居民膳食结构、抽检情况等因素综合分析,健康风险较低,但反映该食品卫生状况不达标。本次监督抽检发现 1 批次方便食品存在大肠菌群超标的情况,原因可能由于产品的加工原料、包装材料受污染,或在生产过程中产品受人员、工器具等生产设备、环境的污染,或有灭菌工艺的产品灭菌不彻底而导致。
菌落总数
菌落总数是指示性微生物指标,并非致病菌指标。主要用来评价食品清洁度,反映食品在生产过程中是否符合卫生要求。菌落总数超标的情况说明个别企业可能未按要求严格控制生产加工过程的卫生条件,或者包装容器清洗消毒不到位;还有可能与产品 包装密封不严、储运条件控制不当等有关。
防腐剂

防腐剂可以抑制食品腐败菌的生长,延长食物的保质期,避免因食品腐败导致的食品安全问题。本次监督抽检发现有 1 批次方便食品存在超范围使用山梨酸及其钾盐的情况。原因可能是企业为延长产品保质期,或者弥补产品生产过程卫生条件不佳而超范围使用防腐剂,或者未准确计量用量。
来源:玉林广播电视报
大事件综合编辑(版权归原作者)
法律顾问:蓝庆球律师 广西金大地律师事务所